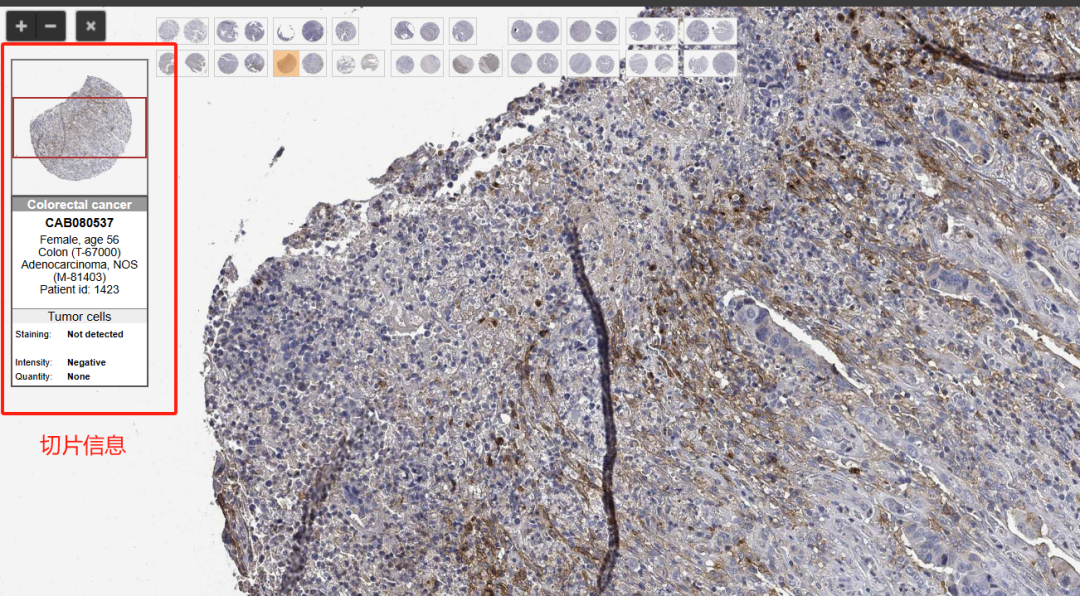

分子生物学



有没有遇到这样的情况,看到一个感兴趣的蛋白,想知道它在哪些细胞和组织中表达。
除了在文献库检索一篇篇地看文献,还可以利用数据库检索!!
给大家介绍一个很好用的蛋白数据库:THE HUMAN PROTEIN ATLAS。不需要注册就可以直接使用。

打开网页我们可以马上看到搜索栏,直接输入感兴趣的蛋白名称,我们以PD-L1为例,进行检索。
注意有的蛋白名字很多,它不一定会显示你最初输入的那一个名字,
如这里,显示的就是PD-L1的另一个名字CD274。
可以看到有的格子上面有绿色的半圆或者完整的圆形,圆形越完整,代表这个数据可信度越高。最可信是完整的圆形(enhanced),其次是3/4(supported),1/2(approved),1/4(uncertain)。


我们直接点击CD274进入详情页面,就可以看到很多详细的信息。首先网页默认进入summary的界面,我们可以看到CD274的基本情况,可以找到我们一开始输入的PD-L1是它的一个别名。


下面几个灰色的框可以查看基本情况。例如:Tissue profile可以看到PD-L1在组织的概况,主要在免疫细胞亚群以及滋养层细胞表达。
如果需要看得详细的情况我们可以继续探索其他的界面。点tissue这里,可以看看这个蛋白在组织的具体情况。

图中会同时展示RNA水平和蛋白水平的情况,我们要明确一点就是RNA水平跟蛋白水平并非强烈相关一致的。
比如内分泌组织的RNA水平表达高,但是蛋白水平表达却很低。右边图中的人体展示目的蛋白在体内的表达情况,颜色越深代表的表达量越高。

右侧一栏的IHC结果图都是可以点开的,打开即可看到高清的染色结果。

点开IHC结果图以后,右侧会标明切片的样本来源是什么,染色的详情。

回到刚刚的页面,再往下可以看到PROTEIN EXPRESSION OVERVIEW,可以展示在各个器官中目的蛋白的表达情况。
鼠标放到柱子上可以看到数据的详情,也可以直接点击柱子,会看到更多详细情况,包括各种切片染色等等。
但是需要注意的是,没有柱子的器官不一定是不表达的器官,也有可能是还没有人研究,所以没有数据可以提供。


(鼠标放在柱子上显示的信息)
接下来我们可以点击subcell看看细胞定位的情况,可以看到绿色的就是有检测到目的蛋白表达的位置。Reliability score一栏看到注明了半个圆形,这里也是表示数据的可靠程度。

点击antibodies这里还可以看到有哪些已经验证过的抗体。需要检测这个蛋白就可以参考这里的抗体。

点击cell line这里,还可以查看各种细胞系里的表达情况。注意这里提供的也是RNA水平的数据。
